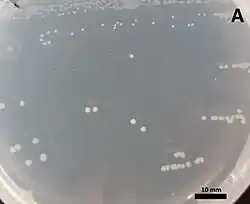

Massilia arenosa
| Massilia arenosa | ||
|---|---|---|
![]() | ||
| Taxonomía | ||
| Dominio: | Bacteria | |
| Reino: | Pseudomonadati | |
| Filo: | Pseudomonadota | |
| Clase: | Betaproteobacteria | |
| Orden: | Burkholderiales | |
| Familia: | Oxalobacteraceae | |
| Género: | Massilia | |
| Especie: |
Massilia arenosa Raths et al. 2020 | |
Massilia arenosa es una bacteria gramnegativa del género Massilia. Fue descrita en el año 2020, aunque inicialmente se aisló en el 2015. Su etimología hace referencia a arena.[1] Es aerobia y móvil. Tiene un tamaño de 0,4 μm de ancho por 1,6 μm de largo. Forma colonias circulares, elevadas, con márgenes enteros y de color cremoso en agar R2A tras 3 días de incubación. Crece de forma individual o en parejas. Temperatura de crecimiento entre 21-30 °C. Es resistente a vancomicina y rifampicina. Contiene genes promotores del crecimiento de plantas. Tiene un genoma de 5,02 Mpb y un contenido de G+C de 66,2%. Se ha aislado del suelo en un campo de maíz en California, Estados Unidos.
Referencias
- ↑ Raths, Rachel; Peta, Vincent; Bücking, Heike (2020-06). «Massilia arenosa sp. nov., isolated from the soil of a cultivated maize field». International Journal of Systematic and Evolutionary Microbiology 70 (6): 3912-3920. ISSN 1466-5034. PMID 32511088. doi:10.1099/ijsem.0.004266. Consultado el 4 de febrero de 2023.